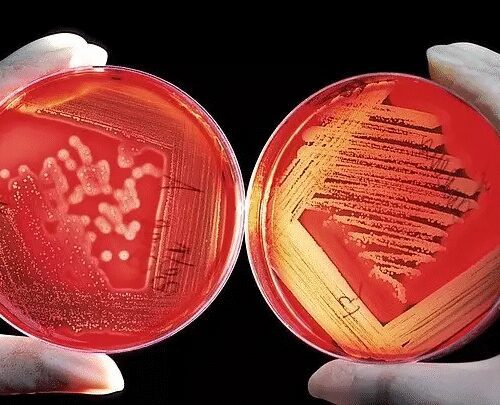
Two red agar petri dishes showing bacterial growth patterns held by gloved hands against a dark background.

Plastic Industry News
Check back frequently to learn about informative stories and breaking information regarding plastic. From the introduction of new technologies to information about legislation and regulations to the most unexpected applications for plastic, we intend to share the latest plastic industry news as quickly as it happens.
Expert Info
We want to open up the field of plastics to everyone. To do that, we invite you to learn more about the variety of methods used to fabricate and form plastic. Let us detail the ins and outs of thermoforming, a heating method that we use to shape polycarbonate and other plastics, and CNC Laser Processing, a precise form of cutting.
Discover how often plastic touches your daily life, as well. You might be amazed to realize that plastic is a popular material in aerospace and aircraft components. You use it every time you play a video game, watch a DVD, or put on your eyeglasses, too.
Plastic might seem like it’s not a big deal to everyday life, but its ability to survive high impacts, high pressure, and high temperatures makes it a magical material. At Polymershapes, we use it to protect the windows on armored vehicles, we create prototypes, and we fabricate essential pieces for the construction industry.
An Array of Applications
Speaking of the versatility of plastic, it lends itself to a variety of applications. People come up with a new possibility for plastic nearly every day. Anytime something big happens in plastic industry news, we want to share it with you. You never know what piece of news might spark an idea of your own.
Stay updated on plastic industry news and the latest advances in technology. Reach out to Polymershapes to ask questions and to share ideas.